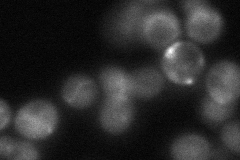

View description
Protein involved in iron metabolism in mitochondria; similar to NifU, which is a protein required for the maturation of the Fe/S clusters of nitrogenase in nitrogen-fixing bacteria
Localization:
Intensity:
Fold change:
Significance:
-
C’ GFP library in SD

mitochondria79.61 -
N' NOP1pr-GFP in SD

mitochondria122.798 -
N' TEF2pr-mCherry in SD

mitochondria119.39 -
N' NATIVEpr-GFP in SD
cytosol,mitochondria45.2962 -
N' TEF2pr-VC and Cyto-VN in SD

#N/A0 -
C’ GFP library in SD+DTT

mitochondria87.041.09No -
C’ GFP library in SD+H2O2

mitochondria89.071.11No -
C’ GFP library in Starvation Media

mitochondria70.180.88No -
C’ GFP library on the background of Pup2-DaMP

N/A -
C’ GFP library on the background of CCT mutant

N/A0N/AYes
